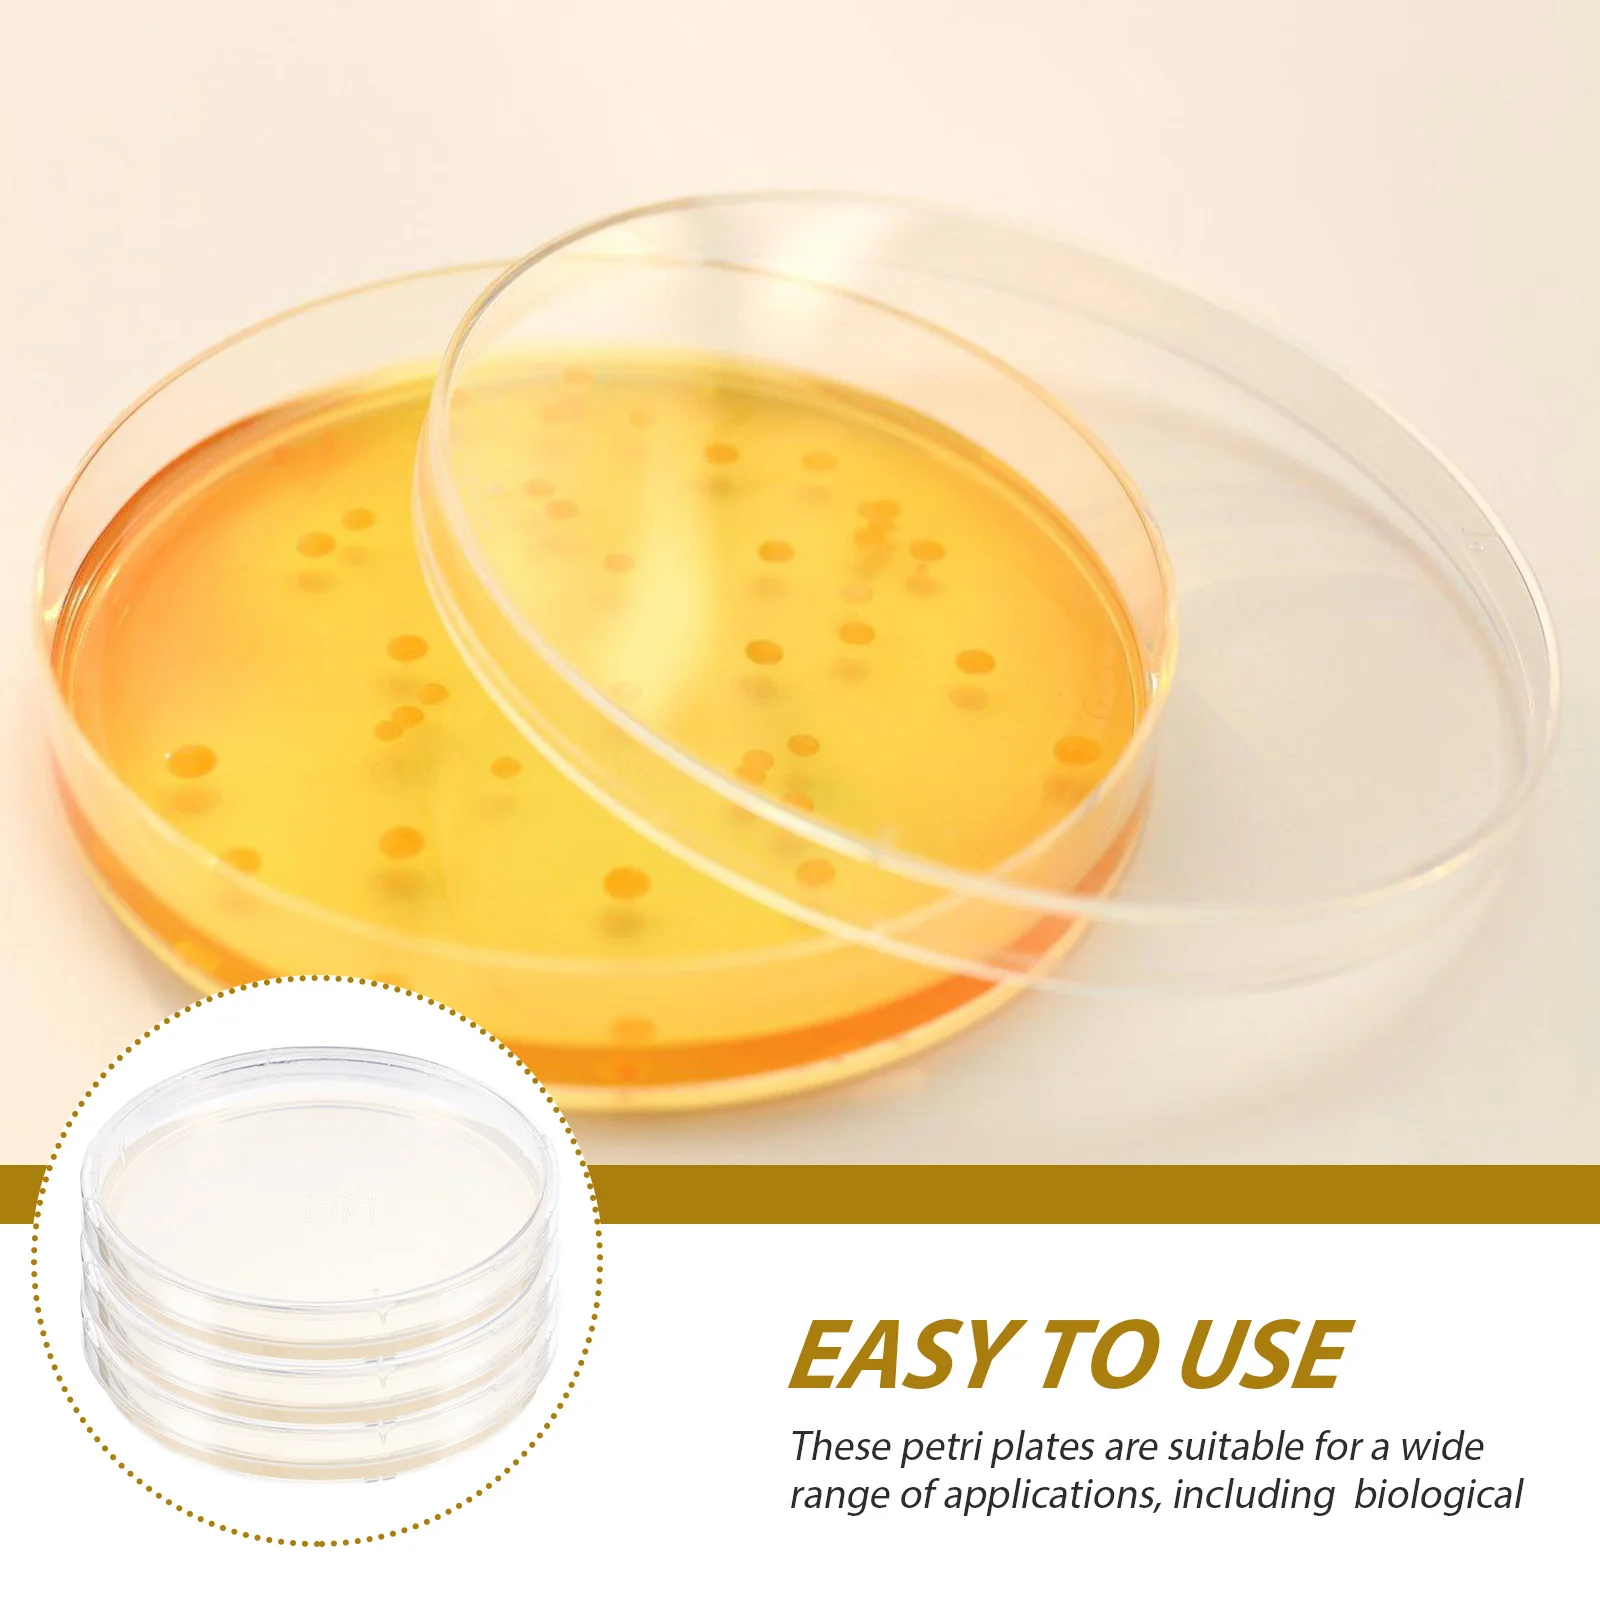
10pcs Agar Plates Bacteria Culture Medium Pre-Poured Petri Dishes For Science Experiments Laboratory Use Biology

Oishi Suky Suky Seaweed Flavor Rasa Rumput Laut 10 GRAM
График изменения цены & курс обмена валют
Пользователи также просматривали

$2.67
Gasket Petrol Fuel Seal Kit Pack Replace Replacement Rubber Seal Sealing Set Accessories For Petrol Canister For 5/10/20 Litre
aliexpress.com
$15.23
Новый инжектор дизельного топлива DSLA128P1510 0433175449 OE 6754-11-3011 для инжектора 0445120059 231, производство Китай
aliexpress.ru
$19.01
Детские шахматные стропы, быстрые игры, настольная деревянная настольная игра, настольная игра, победитель, битва, взрослые интерактивные игрушки, шахматный Хоккей
aliexpress.ru
$11.99
Квадратные Солнцезащитные очки, мужские маленькие очки в оправе, мужские солнцезащитные очки в стиле ретро, зеркальные модные женские очки, оптовая продажа для мужчин
aliexpress.ru
$11.28
Красочная подводка для глаз Pen макияж для глаз белый розовый водостойкий потостойкий жидкий лайнер для глаз Карандаш Косметика для макияжа матовая подводка для глаз
aliexpress.ru
$8.62
4 шт. крышка с отверстием для раковины, заглушки, декоративная крышка для раковины, сделайте раковину пустой
aliexpress.ru
$3.69
2 шт. коробка для сокровищ, стеклянные прозрачные украшения для детей, винтажные стеклянные украшения, коробка для хранения, пиратское сокровище
aliexpress.ru
$5.02
Merry Christmas Rectangular Tablecloths Table Cloth Wedding Decoration Party Events Birthday Outdoor Picnic Mat
aliexpress.com
$36.02
2X Mass Air Flow Sensor Meter MAF 5WK9600 5WK9600Z 5WK9617 13621703275 13621703650 1703650 For BMW E36 E38 E39 Z3 M3
aliexpress.com
$9.53
Classic Dog Clothes Warm Puppy Outfit Pet Jacket Coat Winter Dog Clothes Soft Sweater Clothing For Small Dogs Chihuahua 25S1
joybuy.com
$200.00
Lumin JSD-520 Head Unit Single Din Stereo Dengan Radio FM USBSDAUXBluetooth Handsfree Untuk Mobil
joybuy.com
$200.00
Lumin JSD-520 Head Unit Single Din Stereo Dengan Radio FM USBSDAUXBluetooth Handsfree Untuk Mobil
joybuy.com
$1.10
Yinuoda Fireman hero firefighter phone case for xiaomi redmi 7 5plus 6pro 6a 4x go note5 note7 note6pro mi8se 9se coque
aliexpress.com
$10.45
Ожерелье женское из титановой стали, милое крутое острые ювелирные украшения в стиле девушки, летняя цепочка до ключиц с бисером улучшенног...
aliexpress.ru
$20.45
2021 oblique designers bucket hat women hats and caps patchwork washed denim bucket hat solid wide brim cotton beach two-sided fis303i, Blue;gray
dhgate.com
$21.54
Мини-платье Alien Kitty женское летнее, милый свободный приталенный однотонный шикарный офисный сарафан принцессы с летящим рукавом, 2022
aliexpress.ru
$73.36
jean summer male-tide shorts... korean version of the trend... five stitches... pants denim hip hop men's boy-sized pants. f08z, Blue
dhgate.com
$52.02
Новинка, Женская коллекция 2021, женский плащ, длинный секционный, однотонный, светильник, цветной, повседневный
aliexpress.ru
$4.64
butterfly Phone Case For iphone 11/12 Pro 11Pro/12Pro Max mini 6 7 8 6s Plus Case For iphone X XR XS max SE 2020 Apple Cover
aliexpress.com
$70.27
Free Shipping A Set (Include 6 Pieces) Inflatable Air Track Cheerleading Gymnastics Air Mats + Free One Pump
dhgate.com
$16.34
Gel Pet Ice Silk Cushion Dog Kennel Summer Cooling Mat Pet Cooling Mat Dog Bed Cat Cat
aliexpress.com
$14.89
ABS Carbon Fibre car interior accessories For skoda kamiq 2018 car interior parts Armrests Door Handles For skoda kamiq 2018
aliexpress.com
$8.69
35mm Bearing 31307 27307 E 31307A 31307J2 35x80x22.75 High Quality Single-row Tapered Roller Bearing Cone + Cup
aliexpress.com
$3.49
R-Line1 1M USB Type C Magnetic Cable TOPK R-Line1 Upgraded Reflective Nylon Braided Type-C Cable LED Magnet USB-C Charging Cable
joybuy.com
$19.91
Rococo Style S925 Silver Blue Topaz Lace Adjustable Rings For Women Ins Popular Round Aquamarine Bands Edward Vintage Jewelry
aliexpress.com
$3.59
15pcs Tile Clips Non-Slip Stainless Steel Fix Clamp For Home Roof Supplies Wear-Resistant Metal Roof Clips Replacement Hardware
aliexpress.com
$19.00
2 шт., корпус бокового зеркала из углеродного волокна, черная накладка на зеркало заднего вида для Honda Civic 9 2012 2013 2014 2015, американская версия
aliexpress.ru
$29.79
Коричневый Выделенный Синтетический Парик Длинные Прямые Многослойные Парики с Челкой Омбре Шоколадно-Коричневый Косплей Парики Из Волос Парики Термостойкие
joom.ru
$428.37
NEW CENAVA 4 Inch Logistic Warehouse PDA Barcode Scanner Mobile Data Collector Android 9 Handheld Terminal
aliexpress.com